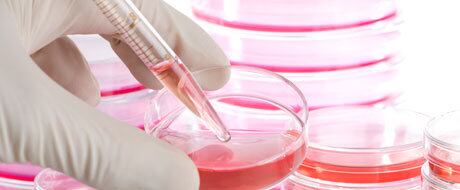
Nove das maiores indústrias farmacêuticas do mundo participam do consórcio

Unicamp entra em grupo global de pesquisa
Universidade pode ser o 1º centro voltado para o desenvolvimento de fármacos no Hemisfério Sul
Educação|Do R7
Imagine um mundo onde a indústria farmacêutica emprestasse algumas de suas ferramentas mais exclusivas para pesquisadores no mundo todo, de graça, para trabalharem com elas à vontade, sem amarras contratuais nem pagamento de royalties. Parece ficção científica, mas esse mundo existe, e o Brasil pode estar prestes a se tornar um protagonista dentro dele.
O tíquete de entrada seria uma parceria entre a Unicamp (Universidade Estadual de Campinas) e o SGC (Structural Genomics Consortium), um consórcio internacional de empresas e cientistas voltado para o desenvolvimento de novos fármacos. Nove das maiores indústrias farmacêuticas do mundo — como Pfizer, Bayer e GSK — participam do consórcio, que tem duas bases de operação: a Universidade de Toronto, no Canadá, e a Universidade de Oxford, na Grã-Bretanha. O plano, agora, é incluir a Unicamp nessa lista, como o primeiro centro da rede no Hemisfério Sul.
— A ideia é montar um centro verdadeiramente internacional, para produzir ciência de alto nível, orientada por metas específicas — disse o biólogo Paulo Arruda, professor da Unicamp e um dos pioneiros da biotecnologia no Brasil.
O núcleo campineiro seria o primeiro da rede, também, a trabalhar com pesquisas para o setor agrícola, além do farmacêutico.
— Será uma oportunidade fantástica de colocar as duas coisas sob um mesmo teto, com cientistas da área farmacêutica e da área de biotecnologia agrícola trabalhando lado a lado — conta o biólogo.
Um acordo já foi assinado, e a Unicamp se comprometeu a criar espaço para o futuro laboratório, que, segundo Arruda, deverá empregar 25 pesquisadores. Só falta o dinheiro: R$ 11 milhões (US$ 5 milhões) para os primeiros cinco anos, que os organizadores estão tentando levantar com empresas do setor e agências de fomento. É o mesmo valor que cada empresa paga para participar do consórcio.
Diferencial
O foco científico do SGC é a pesquisa da estrutura e função de pequenas moléculas (chamadas "sondas"), que inibem a função de proteínas relacionadas a doenças e, por isso, servem como ferramentas essenciais para o desenvolvimento de novos fármacos. "Vamos testar essas moléculas inibidoras também em plantas", adiantou Arruda.
O diferencial do consórcio é que ele opera num sistema de pesquisa "aberta", no qual empresas e pesquisadores acadêmicos compartilham informações livremente para o avanço da ciência básica, sem patentes, royalties ou contratos de exclusividade. "O princípio básico da parceria é simples: nada de patentes, só ciência", diz o diretor do SGC, Aled Edwards.
Ele explica que as empresas farmacêuticas são as únicas que detêm o expertise e os recursos necessários para desenvolver essas sondas (ao custo de mais de US$ 2 milhões cada), mas não têm cientistas suficientes para testar todas elas contra diferentes alvos biológicos. A solução proposta pelo consórcio é colocar essas moléculas em domínio público, para que qualquer cientista possa trabalhar com elas. Se essas pesquisas revelarem algum efeito terapêutico importante, as indústrias poderão, então, disputar uma corrida entre elas para ver quem consegue desenvolver o medicamento primeiro.
Os cientistas se beneficiam do acesso às ferramentas e a indústria, do conhecimento gerado com base nelas. Em vez de as empresas competirem entre elas desde os estágios iniciais de pesquisa básica, elas passam a competir apenas em um estágio mais avançado de pesquisa aplicada", diz Edwards. Com isso, diz ele, reduz-se significativamente os riscos e os custos do processo de desenvolvimento de novos fármacos.
Seja bombardead@ de boas notícias. R7 Torpedos
Moda, esportes, política, TV: as notícias mais quentes do dia














